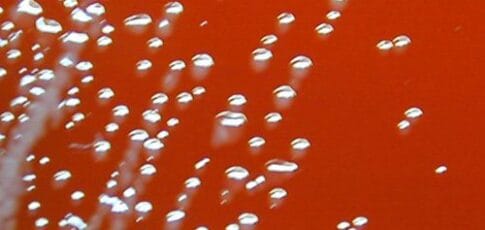
Two men fell gravely ill last year; their infections link to deaths in the ’80s

An inner-speech decoder reveals some mental privacy issues
August 23, 2025

Apple reportedly prepping enterprise AI support beyond ChatGPT
August 23, 2025

Gemini letting anyone generate Veo 3 videos this weekend
August 22, 2025

Bluesky blocks Mississippi under new age verification law
August 22, 2025